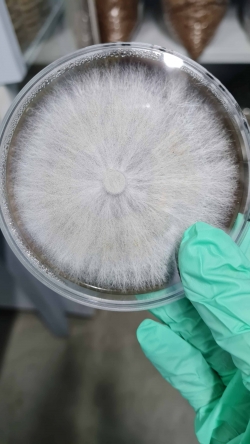

12.04.2022 Группа ученых Новосибирского ГАУ посетила компанию ООО «Сибирская Грибная Поляна» с целью возможного дальнейшего сотрудничества

12 апреля группа ученых Новосибирского ГАУ, во главе с ректором Евгением Рудым, посетила компанию ООО «Сибирская Грибная Поляна» с целью возможного дальнейшего сотрудничества.
Сотрудники компании провели экскурсию для ученых НГАУ на базе собственного производства грибов. Рассказали всю технологию выращивания шампиньонов, что такое компост фазы 2, чем он отличается от компоста фазы 3, как выращивать на покупном компосте и почему необходимо использовать определенный торф.
В ходе встречи обсуждались вопросы о теоретическом и практическом обучении студентов, которые в дальнейшем будут работать на предприятиях по выращиванию грибов.
Также ООО «Сибирская Грибная Поляна» предлагает студентам пройти производственную практику на их предприятии, получить большой опыт и знания. Благодаря такому подходу легко запомнить не только теоретическую информацию, но и выработать практические навыки на все технологические процессы, а также возможность увидеть собственными глазами, что такое промышленное грибоводство.